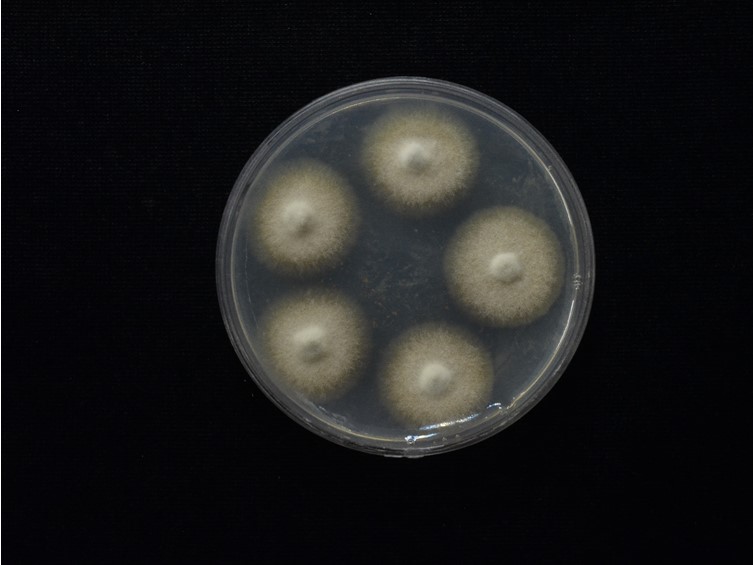

Holotype:
LAOS, Vientiane Province, Ban Dan xang district, 31 Aug. 2016, P. Nupason, K. Keochanpheng, J.J. Luangsa-ard, S. Mongkolsamrit, W. Noisripoom, D. Thanakitpipattana, holotype BBH 43166, ex-type living culture TBRC 8428.
Habitat:
Buried in the soil.
Host:
Coleoptera larva.
Description:
 Stroma solitary, up to 11 cm long and 1.5-2.5 mm in width, cylindrical, cream, stipe simple. Rhizoids flexuous, arising from the head of Coleoptera larva, ca 2-6 cm long buried under the ground.
Stroma solitary, up to 11 cm long and 1.5-2.5 mm in width, cylindrical, cream, stipe simple. Rhizoids flexuous, arising from the head of Coleoptera larva, ca 2-6 cm long buried under the ground.  Fertile part distinctly subterminal with asexual morph at apex. Ascomata subterminal, cylindrical, pale yellow-brown with dark brown ostioles, 10-30 mm long, 2-3 mm in width.
Fertile part distinctly subterminal with asexual morph at apex. Ascomata subterminal, cylindrical, pale yellow-brown with dark brown ostioles, 10-30 mm long, 2-3 mm in width.  Perithecia completely immersed, obclavate, 300-450 × 80-170 μm.
Perithecia completely immersed, obclavate, 300-450 × 80-170 μm.  Asci cylindrical, 100-250 × 4-7.5 μm.
Asci cylindrical, 100-250 × 4-7.5 μm.  Ascospores hyaline, cylindrical, breaking into 32 small truncate part-spores, 4-7 × 1-2 μm. Asexual morph terminal, whitish to pale yellow, up to 10 mm long, 0.5-1 mm in width. Conidiogenous cells monophialidic, phialides flask-shaped with long necks, up to 30 μm long and 2-4 μm in width; phialide necks up to 18 μm long and 0.5 μm in width. Conidia hyaline, smooth, spherical, 2-3 μm.
Ascospores hyaline, cylindrical, breaking into 32 small truncate part-spores, 4-7 × 1-2 μm. Asexual morph terminal, whitish to pale yellow, up to 10 mm long, 0.5-1 mm in width. Conidiogenous cells monophialidic, phialides flask-shaped with long necks, up to 30 μm long and 2-4 μm in width; phialide necks up to 18 μm long and 0.5 μm in width. Conidia hyaline, smooth, spherical, 2-3 μm.
Culture characteristics:
Colonies on PDA moderately growing, ca 1 cm diam in 21 d at 25 °C. Colonies white, reverse pale brown. Asexual morph Hirsutella-like, observed in some strains. Conidiogenous cells monophialidic, 15–34 × 3–5 μm, necks present, 7–21 × 0.5 μm. Conidia hyaline, smooth, spherical, 3–5 μm.
Colonies on PDA moderately growing, ca 1 cm diam in 21 d at 25 °C. Colonies white, reverse pale brown. Asexual morph Hirsutella-like, observed in some strains. Conidiogenous cells monophialidic, 15–34 × 3–5 μm, necks present, 7–21 × 0.5 μm. Conidia hyaline, smooth, spherical, 3–5 μm.
Reference:
Crous PW, Luangsa-ard JJ, Wingfield MJ, et al. (2018). Fungal Planet description sheets. Persoonia 41: 238–417.
DOI: https://doi.org/10.3767/persoonia.2018.41.12Species |
Strain |
Compound |
Pubchem CID |
Biological activity |
Reference |
|---|
|
Strain |
ITS | LSU | TEF1 |
|---|---|---|---|
| BBC 82809 | MH092892 | MH092908 | MH092899 |
| BCC 78167 | - | MH092905 | MH092898 |
| BCC 78421 | - | MH092904 | MH092897 |
| BCC 82810 | MH092893 | MH092909 | MH092900 |
| TBRC 8428 | MH092891 | MH092902 | MH092894 |